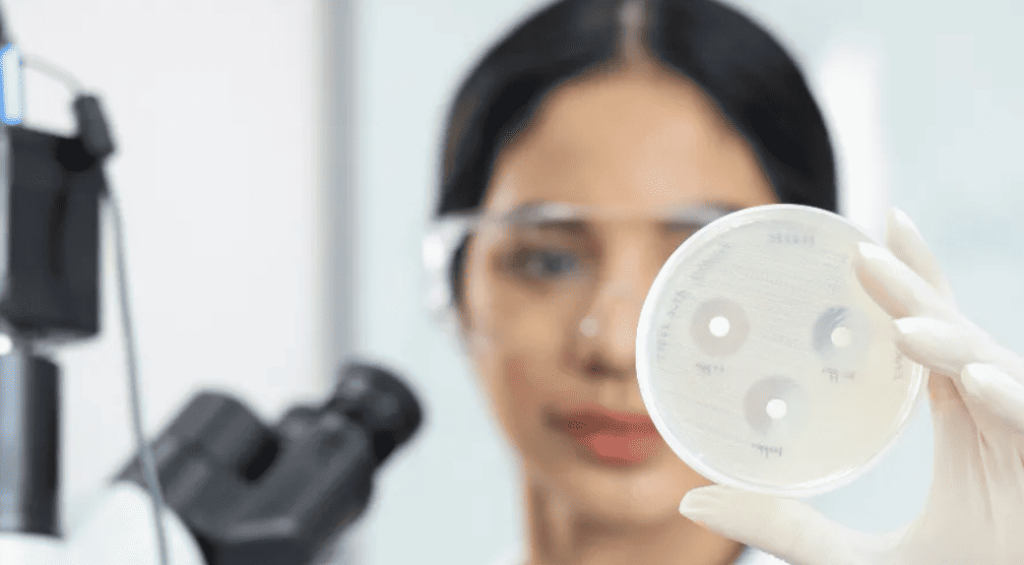
Screenshot-2023-11-20-100847

In February 1941, Albert, a 43-year-old policeman from the UK, scratched his face on a rose bush. The simple wound became severely infected. He was the first patient receiving penicillin treatment. Unfortunately, the quantity of penicillin was not enough, and he died. Penicillin became available to the public in 1946 and since then 20 new classes of antibiotics have been discovered.
But today bacteria have become increasingly resistant to penicillin and many other antibiotics (antimicrobial resistance or AMR). AMR is dramatically spurred by the overuse and misuse of antimicrobials in people, animals, and plants. A post-antibiotic era may become a reality as finding a new antibiotic is more challenging while drug resistance rapidly increases.
A world without effective antibiotics would plunge humanity back into an era of health uncertainty. Tuberculosis (TB), staph infections, and strep infections—conditions currently treated by antibiotics— could become deadly. We would lose at least 20 years of life expectancy.
AMR is a leading global health issue and could jeopardize global development goals
It is estimated that, annually , 5 million deaths are associated with AMR and 1.3 million deaths are directly attributable to AMR Compared with all underlying causes of deaths, AMR would be the 3rd leading cause, only behind ischemic heart disease and stroke (Lancet, 2019). Alarmingly, the latest data also show AMR deaths were highest in some low- and middle-income countries (LMICs). Of the 5 million deaths, 1.4 million were from South Asia, 1.1 million from sub-Saharan Africa. (Figure 1).
Figure 1: Deaths associated with AMR by region (in thousands)
.png)
Unchecked AMR would disproportionately affect low- and middle- income countries, hampering progress towards the Sustainable Development Goals. World Bank simulations (2017) found that, AMR could cause large economic losses, more than $1 trillion annually (compared to the 2008 global financial crisis). Low-income countries would experience larger drops in economic growth and the impacts of AMR on gross domestic product (Figure 2). For example, high rates of AMR could lead to an additional 28 million people living in extreme poverty in 2050, the vast majority (26 million) of which would live in low-income countries. The World Bank’s goal of ending poverty by 2030 as well as many SDG goals would be jeopardized.
Figure 2: Highest economic losses due to AMR are among low-income countries (%)_0.png)
The theme for this year’s AMR Awareness Week, “Preventing Antimicrobial Resistance Together,” calls for collaboration across sectors to fight AMR and preserve the efficacy of critical antibiotics – a global public good. AMR is a complex development challenge that affects whole societies and is driven by multifaceted factors related to people, animals, plants, and ecosystems. Single, isolated interventions will have limited impact.
Mitigating impact of AMR through One Health: Examples of World Bank financing in India
Today, India is one of the most AMR-affected countries in the world. India’s top 10 killers include diarrhea diseases (#4), lower respiratory infections (#6), and TB (#7). These are the top diseases impacted by the rise of AMR, especially drug-resistant TB (DR-TB) which is estimated to account for a third of the total AMR burden. India is a high TB and DR-TB burden country, making up nearly one-third of global TB’s cases. Furthermore, with over 8,000 pharmaceutical manufacturers in India, the release of pharmaceutical and hospital waste products into the water systems has exacerbated the issue.
To mitigate the impact of AMR, India has adopted a coordinated One Health approach—an integrated approach to sustainably balance and optimize the health of people, animals and ecosystems. The National One Health Mission is a cross-cutting initiative bringing together multiple stakeholders, including different ministries, academic institutions, NGOs and civil society. AMR surveillance is an integral part of this broad-based initiative.
The World Bank is an active partner in India’s journey to manage AMR. The World Bank financing through the $500 million Transforming India’s Public Health System’s for Pandemic Preparedness Program includes support for the National Center for Disease Control to enhance the effectiveness of the national program on AMR containment. This includes publication of twice-yearly AMR bulletins, reactivation of an intersectoral committee on AMR, and expansion of the national AMR surveillance network by five-fold over the next few years.
Similarly, the World Bank’s $82 million support for the India Animal Health System Support for Improved One Health project strengthens India’s institutional capacity to effectively deliver animal health services to livestock farmers. Under the aegis of the World Bank’s $105 million in financing for the Innovate in India for Inclusiveness project, the Biotechnology Industry Research Assistance Council has accorded high priority to the development of diagnostics to detect anti-microbial resistant pathogens. This will improve the availability of critical medical countermeasures.
Curbing AMR is one step to achieving our goal of ending poverty in a livable planet. A silver lining is that this is possible by working together under a coordinated One health platform.
Source : World Bank